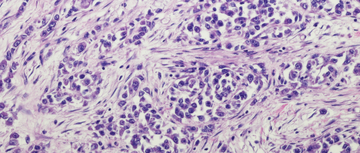

Drug Updates Articles

Pharmacist's Application to Practice: Zenocutuzumab-zbco
Allen Barry, MBA, PharmD Candidate Class of 2025, and Alisha Vora, PharmD, BCOP, CPP, Clinical Pharmacist Practitioner, Gastrointestinal Medical Oncology - both from the University of North Carolina, Chapel Hill, NC - write about zenocutuzumab-zbco.

Pharmacist's Application to Practice: Sacituzumab govitecan-hziy
Brooke Kielkowski, PharmD, PGY2 Oncology Pharmacy Resident, and Jordan Hill, PharmD, BCOP, Pharmacy Clinical Specialist, both from WVU Medicine - West Virginia University Hospitals, Morgantown, WV, write about sacituzumab govitecan-hziy (Trodelvy).

Pharmacist's Application to Practice: Zolbetuximab-clzb
Olivia Tholt, PharmD, PGY2 Oncology Pharmacy Resident, and Sarah Cimino, PharmD, BCOP, Clinical Pharmacist Specialist, Gastrointestinal Oncology, both from Vanderbilt University Medical Center, Nashville, TN, write about zolbetuximab-clzb (Vyloy).

Pharmacist's Application to Practice: Vorasidenib
Lacy La Fever, PharmD, MS, PGY2 Oncology Pharmacy Resident, and Anastasia Graham, PharmD, MBA, BCOP, Clinical Oncology Specialist, Neuro-oncology, both from Medical University of South Carolina, Charleston, SC, write about vorasidenib (Voranigo).


Pharmacist’s Application to Practice: Axatilimab-csfr
Sydney Hunt, PharmD, PGY-1 Pharmacist Resident, and Lindsay Orton, PharmD, BCOP, Stem Cell Transplant and Cellular Therapy Clinical Pharmacist, both from Vanderbilt University Medical Center, Nashville, TN, write about axatilimab-csfr (Niktimvo).

Pharmacist's Application
to Practice: Nogapendekin
alfa inbakicept-pmln
Devan Parker, PharmD, PGY2 Oncology Pharmacy Resident and Juliana Leedy, PharmD, MS, Clinical Oncology Pharmacist, The University of Alabama at Birmingham (UAB) Hospital, Birmingham, Alabama writes about nogapendekin alfa inbakicept-pmln.